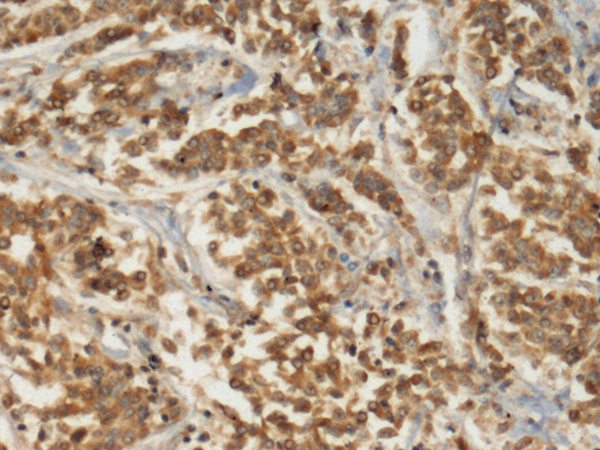
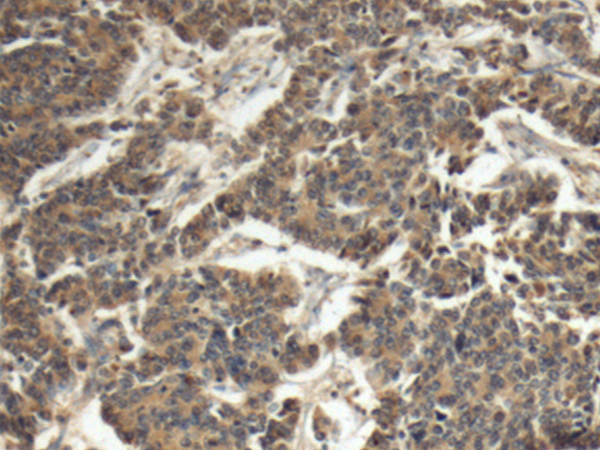
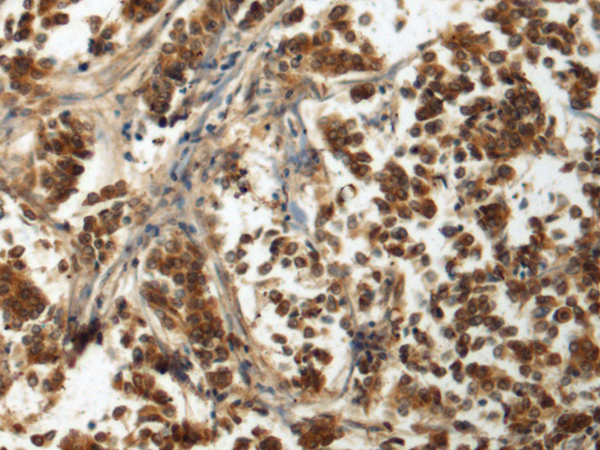

-
分类: 科研抗体货号: P10489别名: JABELS应用: IHC反应种属: Human, Mouse
-
分类: 科研抗体货号: P10479别名: DDX8; Dhr2; HRH1; PRP22; PRPF22应用: IHC反应种属: Human, Mouse
-
分类: 科研抗体货号: P10500别名: DDX57应用: IHC反应种属: Human
-
分类: 科研抗体货号: P10488别名:应用: WB,IHC反应种属: Human, Mouse
-
分类: 科研抗体货号: P10475别名: EIF3S4; EIF3-P42; eIF3-p44; eIF3-delta应用: IHC反应种属: Human, Mouse, Rat
-
分类: 科研抗体货号: P10496别名: H4C2; H4C3; H4C4; H4C5; H4C6; H4C8; H4C9; H4FA; H4-16; H4C11; H4C12; H4C13; H4C14; H4C15; HIST1H4A应用: WB,IHC反应种属: Human, Mouse
-
分类: 科研抗体货号: P10487别名: VHY; C20orf57应用: WB,IHC反应种属: Human, Mouse, Rat
-
分类: 科研抗体货号: P10508别名: GTM5; GSTM5-5应用: WB,IHC反应种属: Human, Mouse
-
分类: 科研抗体货号: P10495别名: IPPI2应用: WB,IHC反应种属: Human
-
分类: 科研抗体货号: P10507别名: IRBP; RBPI; RP66; D10S64; D10S65; D10S66应用: IHC反应种属: Human

鄂公网安备42018502007531号
鄂公网安备42018502007531号

